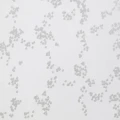
Rain natural sadetapetti Mimoulta

Rain wallpaper
Mimou
On Mimou's Rain wallpaper, the rain drops down and forms medallion patterns. The wallpaper is calm and suitable both as a feature wall and for the entire room. Can be matched with Mimou's Rain Birds.
Three color options.
Product Code:
Lowest price from the past 30 days
56,70 €
Price now
Specifications
Tags:
Style:
Commas and circles,
Other patterns
Material:
Non woven
Roll length:
10.05 m
Roll width:
53 cm
Pattern repetition:
53 cm
Care instructions:
colorfast
Environment & labels:
FSC-certified,
OEKO-TEX Standard 100
Light fastness:
Good lightfastness 5-6
Fire class:
category B-s1, d0
Country of manufacture:
Sweden

Psst. Alvar - your AI assistant made these suggestions for you!
Psst. Alvar - your AI assistant made these suggestions for you!






